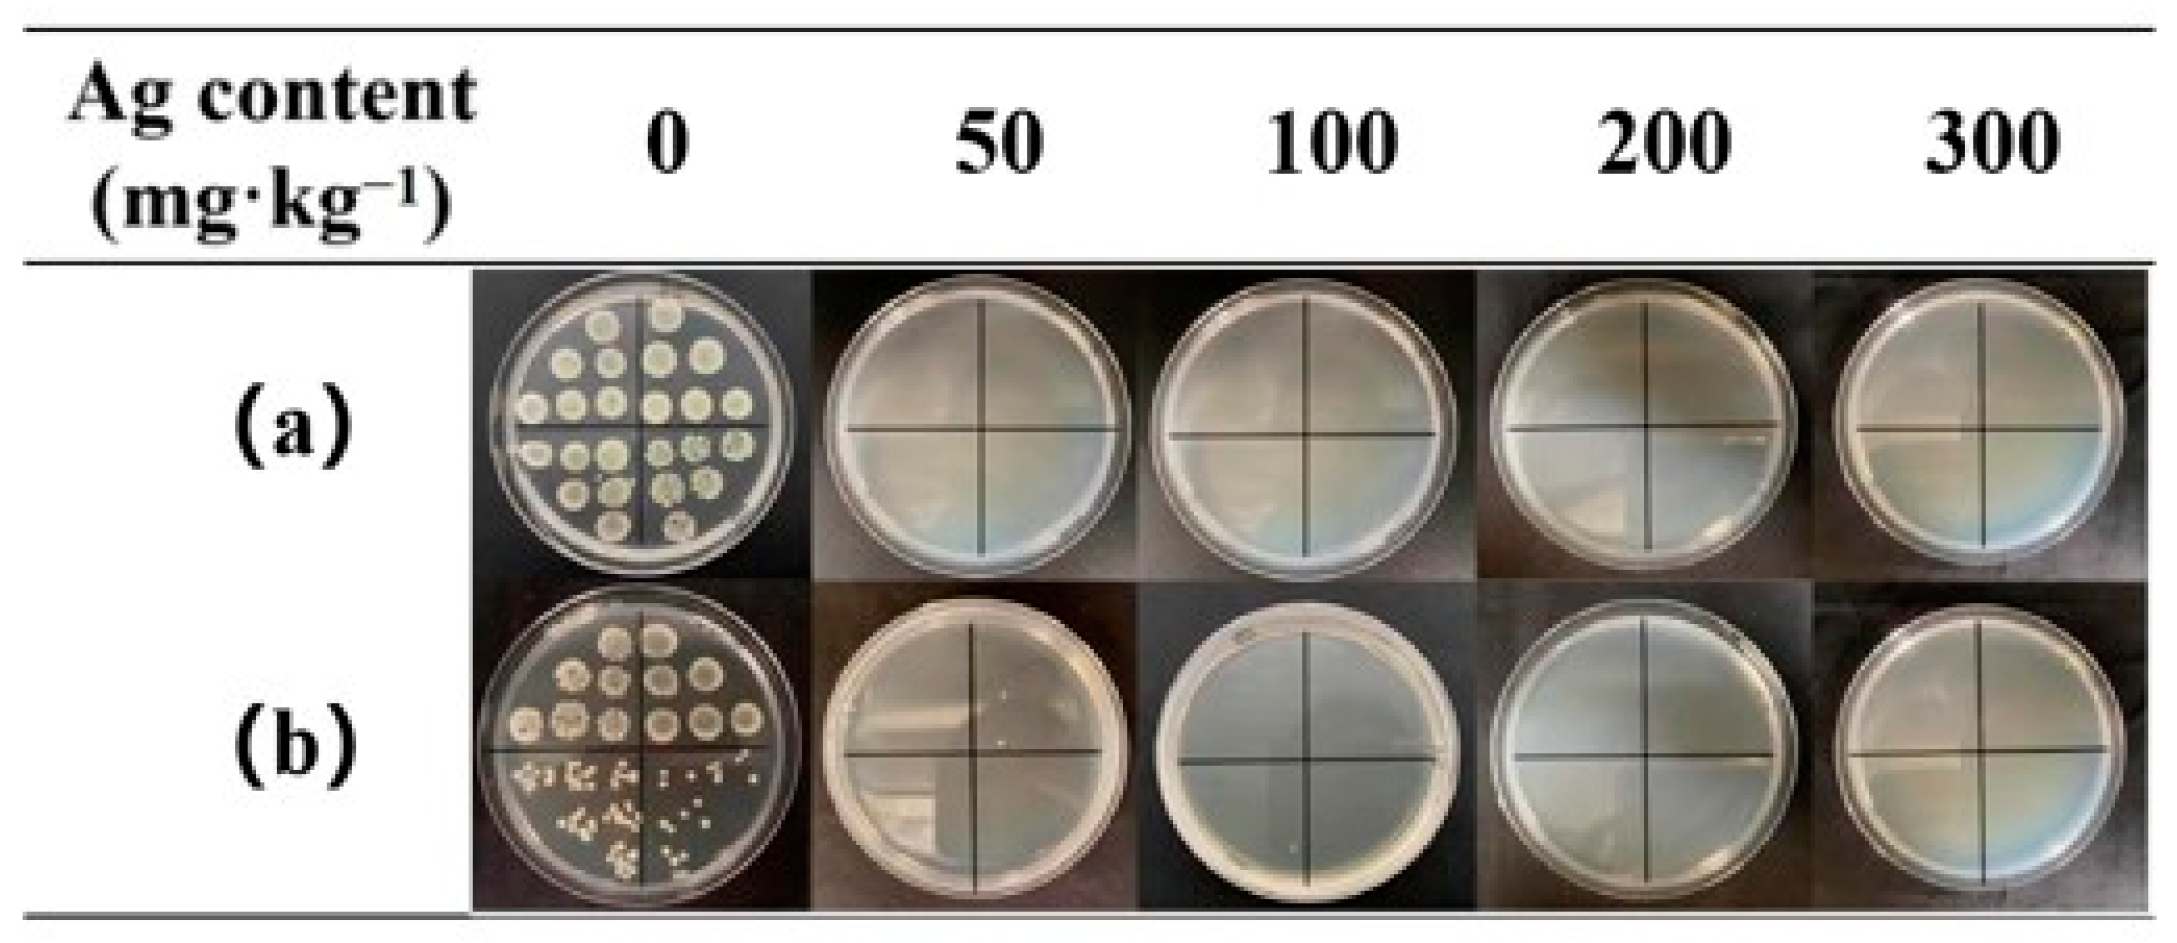
Nanomaterials 12 01813 g006

Waterproof and Moisture-Permeable Polyurethane Nanofiber Membrane with High Strength, Launderability, and Durable Antimicrobial Properties
Abstract
:1. Introduction
2. Materials and Methods
2.1. Chemicals
2.2. Preparation and Characterization of WPU-Capped AgNPs
2.3. Preparation and Characterization of AgNP-Embedded TPU Nanofiber Membrane
2.4. Release Kinetics of Silver Ions
2.5. Antibacterial Tests
2.6. Waterproof and Moisture Permeability Test
2.7. Wash Resistance Test
3. Results and Discussion
3.1. Preparation and Characterization of WPU-Capped AgNPs
3.2. Preparation and Characterization of AgNP-Embedded TPU Nanofiber Membrane
3.3. Release Kinetics of Silver Ions
3.4. Antibacterial Tests
3.5. Waterproof and Moisture Permeability Test
4. Conclusions
Author Contributions
Funding
Data Availability Statement
Conflicts of Interest
References
- Karim, N.; Afroj, S.; Lloyd, K.; Oaten, L.C.; Andreeva, D.V.; Carr, C.; Farmery, A.D.; Kim, I.; Novoselov, K.S. Sustainable Personal Protective Clothing for Healthcare Applications: A Review. ACS Nano 2020, 14, 12313–12340. [Google Scholar] [CrossRef]
- Li, J.; Liu, X. The Study of Sustainable Strategy in Design of Protective Clothing and Accessories After Coronavirus (COVID-19) Outbreak. J. Phys. Conf. Ser. 2021, 1790, 012027. [Google Scholar] [CrossRef]
- Andrade, F.A.C.; Vercik, L.C.O.; Monteiro, F.J.; Rigo, E.C.S. Preparation, characterization and antibacterial properties of silver nanoparticles–hydroxyapatite composites by a simple and eco-friendly method. Ceram. Int. 2015, 42, 2271–2280. [Google Scholar] [CrossRef]
- Tang, S.; Zheng, J. Antibacterial Activity of Silver Nanoparticles: Structural Effects. Adv. Healthc. Mater. 2018, 7, 1701503. [Google Scholar] [CrossRef] [PubMed]
- Deshmukh, S.P.; Patil, S.M.; Mullani, S.B.; Delekar, S.D. Silver nanoparticles as an effective disinfectant: A review. Mater. Sci. Eng. C 2019, 97, 954–965. [Google Scholar] [CrossRef] [PubMed]
- Hu, G.; Jin, W.; Chen, Q.; Cai, Y.; Zhu, Q.; Zhang, W. Antibacterial activity of silver nanoparticles with different morphologies as well as their possible antibacterial mechanism. Appl. Phys. A 2016, 122, 874. [Google Scholar] [CrossRef]
- Kora, A.J.; Arunachalam, J. Assessment of antibacterial activity of silver nanoparticles on Pseudomonas aeruginosa and its mechanism of action. World J. Microbiol. Biotechnol. 2011, 27, 1209–1216. [Google Scholar] [CrossRef]
- Durán, N.; Durán, M.; Jesus, M.D.; Seabra, A.; Fávaro, W.; Nakazato, G. Silver Nanoparticles: A New View on Mechanistic Aspects on Antimicrobial Activity. Nanomed. Nanotechnol. Biol. Med. 2016, 12, 789–799. [Google Scholar] [CrossRef]
- Shah, A.; Hussain, I.; Murtaza, G. Chemical synthesis and characterization of chitosan/silver nanocomposites films and their potential antibacterial activity. Int. J. Biol. Macromol. 2018, 116, 520–529. [Google Scholar] [CrossRef]
- Deng, X.; Nikiforov, A.; Vujosevic, D.; Vuksanovic, V.; Mugoša, B.; Cvelbar, U.; Geyter, N.; Morent, R.; Leys, C. Antibacterial activity of nano-silver non-woven fabric prepared by atmospheric pressure plasma deposition. Mater. Lett. 2015, 149, 95–99. [Google Scholar] [CrossRef]
- Xu, Q.; Ke, X.; Zhang, Y.; Fu, F.; Liu, X. Facile Fabrication of Durable Antibacterial Cotton Fabric Realized by Thioglycolic Acid and Silver Nanoparticles. Fibers Polym. 2018, 19, 2307–2316. [Google Scholar] [CrossRef]
- Sharma, P.; Pant, S.; Rai, S.; Yadav, R.B.; Sharma, S.; Dave, V. Green synthesis and characterization of silver nanoparticles by Allium cepa L. to produce silver nano-coated fabric and their antimicrobial evaluation. Appl. Organomet. Chem. 2018, 32, e4146. [Google Scholar] [CrossRef]
- Hebeish, A.; El-Naggar, M.E.; Fouda, M.M.G.; Ramadan, M.A.; Al-Deyab, S.S.; El-Rafie, M.H. Highly effective antibacterial textiles containing green synthesized silver nanoparticles. Carbohydr. Polym. 2011, 86, 936–940. [Google Scholar] [CrossRef]
- Salam, A.; Hassan, T.; Jabri, T.; Riaz, S.; Khan, A.; Iqbal, K.M.; Khan, S.U.; Wasim, M.; Shah, M.R.; Khan, M.Q.; et al. Electrospun Nanofiber-Based Viroblock/ZnO/PAN Hybrid Antiviral Nanocomposite for Personal Protective Applications. Nanomaterials 2021, 11, 2208. [Google Scholar] [CrossRef]
- Xu, Q.; Wu, Y.; Zhang, Y.; Fu, F.; Liu, X. Durable antibacterial cotton modified by silver nanoparticles and chitosan derivative binder. Fibers Polym. 2016, 17, 1782–1789. [Google Scholar] [CrossRef]
- Prihandana, G.S.; Sriani, T.; Muthi’ah, A.D.; Machmudah, A.; Mahardika, M.; Miki, N. Study Effect of nAg Particle Size on the Properties and Antibacterial Characteristics of Polysulfone Membranes. Nanomaterials 2022, 12, 388. [Google Scholar] [CrossRef]
- Alfuraydi, R.T.; Alminderej, F.M.; Mohamed, N.A. Evaluation of Antimicrobial and Anti-Biofilm Formation Activities of Novel Poly(vinyl alcohol) Hydrogels Reinforced with Crosslinked Chitosan and Silver Nano-Particles. Polymers 2022, 14, 1619. [Google Scholar] [CrossRef]
- Baldino, L.; Aragon, J.; Mendoza, G.; Irusta, S.; Cardea, S.; Reverchon, E. Production, characterization and testing of antibacterial PVA membranes loaded with HA-Ag3PO4 nanoparticles, produced by SC-CO2 phase inversion. J. Chem. Technol. Biotechnol. 2019, 94, 98–108. [Google Scholar] [CrossRef] [Green Version]
- Brennan, M.E.; Whelan, A.M.; Kelly, J.M.; Blau, W.J. Silver Nanoparticle Self-organization into Dendritic Fractals. Synth. Met. 2005, 154, 205–208. [Google Scholar] [CrossRef]
- Li, T.; Hsu, S.L. Preparation and properties of conductive polyimide nanocomposites with assistance of a metallo-organic compound. J. Mater. Chem. 2010, 20, 1964–1969. [Google Scholar] [CrossRef]
- Lai, W.; Zhao, W.; Li, X. Research Progress of the Controlled Preparation of Nano Silver with Various Morphologies. Rare Met. Mater. Eng. 2011, 40, 1311–1316. [Google Scholar] [CrossRef]
- Reit, R.; Lund, B.; Voit, W. Shape Memory Polymer–Inorganic Hybrid Nanocomposites. Adv. Polym. Sci. 2014, 267, 313–350. [Google Scholar] [CrossRef]
- Kim, J.; Lee, J.; Kwon, S.; Jeong, S. Preparation of biodegradable polymer/silver nanoparticles composite and its antibacterial efficacy. J. Nanosci. Nanotechnol. 2009, 9, 1098–1102. [Google Scholar] [CrossRef]
- Maxwell, M.; Kang, T.; Xinli, Z.; Chia, S.; Zhong, Z. Current Development of Silver Nanoparticle Preparation, Investigation, and Application in the Field of Medicine. J. Nanomater. 2015, 2015, 1–12. [Google Scholar] [CrossRef] [Green Version]
- Liao, L.; Xiong, J.; Xie, K. Study of Preparation of Nano-Silver Powder by Reduction Process in Liquid Phase. Rare Met. Mater. Eng. 2004, 33, 558–560. [Google Scholar] [CrossRef]
- Gai, X.; Liu, Y.; Hong, H.; Wang, K. Progress in Preparation of Phenolic Fibers by Electrospinning. Mater. Sci. Forum 2015, 815, 638–642. [Google Scholar] [CrossRef]
- Shi, J.; Jia, D.; Cheng, B.; Kang, W. The Effect of Electrospinning Parameters on Mophology of PAN/PU Composite Nanofibers. Adv. Mater. Res. 2011, 332–334, 1343–1346. [Google Scholar] [CrossRef]
- Mi, H.; Salick, M.R.; Jing, X.; Crone, W.C.; Peng, X.; Turng, L. Electrospinning of unidirectionally and orthogonally aligned thermoplastic polyurethane nanofibers: Fiber orientation and cell migration. J. Biomed. Mater. Res. Part A 2015, 103, 593–603. [Google Scholar] [CrossRef] [Green Version]
- Damm, C.; Munstedt, H. Kinetic aspects of the silver ion release from antimicrobial polyamide/silver nanocomposites. Appl. Phys. A Mater. Sci. Process. 2008, 91, 479–486. [Google Scholar] [CrossRef]
- Hahn, A.; Brandes, G.; Wagener, P.; Barcikowski, S. Metal ion release kinetics from nanoparticle silicone composites-ScienceDirect. J. Control. Release 2011, 154, 164–170. [Google Scholar] [CrossRef]
- Wen, Z.; Yao, Y.; Sullivan, N.; Chen, Y. Modeling the Primary Size Effects of Citrate-Coated Silver Nanoparticles on Their Ion Release Kinetics. Environ. Sci. Technol. 2011, 45, 4422–4428. [Google Scholar] [CrossRef]
- Feng, J.; Xu, S.; Pan, G.; Yao, L.; Guan, Y.; Zhou, L.; Cui, L.; Yang, Z. Clean preparation of washable antibacterial polyester fibers by high temperature and high pressure hydrothermal self-assembly. Nanotechnol. Rev. 2021, 10, 1740–1751. [Google Scholar] [CrossRef]
- Xu, S.; Zhang, F.; Yao, L.; Zhu, C.; Morikawa, H.; Chen, Y. Eco-friendly fabrication of antibacterial cotton fibers by the cooperative self-assembly of hyperbranched poly(amidoamine)-and hyperbranched poly(amine-ester)-functionalized silver nanoparticles. Cellulose 2017, 24, 1493–1509. [Google Scholar] [CrossRef]
- Teli, M.D.; Sheikh, J. Nanosilver containing grafted bamboo rayon as antibacterial material. Fibers Polym. 2012, 13, 1280–1285. [Google Scholar] [CrossRef]
- Ru, J.; Qian, X.; Wang, Y. Study on antibacterial finishing of cotton fabric with silver nanoparticles stabilized by nanoliposomes. Cellulose 2018, 25, 5443–5454. [Google Scholar] [CrossRef]
- Zhang, F.; Tao, Y.; Chen, S.; Lu, Y. Preparation and properties of the silver loaded activated carbon fibers. Fibers Polym. 2015, 16, 2003–2010. [Google Scholar] [CrossRef]

| Ag Content (mg·kg−1) | Antibacterial Rates (%) | |
|---|---|---|
| Escherichia coli | Staphylococcus aureus | |
| 50 | 90.37 | 97.57 |
| 100 | 99.99 | 99.99 |
| 200 | 99.99 | 99.99 |
| 300 | 99.99 | 99.99 |
| Ag Content (mg·kg−1) | Antibacterial Rates (%) | |
|---|---|---|
| Escherichia coli | Staphylococcus aureus | |
| 50 | 99.99 | 99.99 |
| 100 | 99.99 | 99.99 |
| 200 | 99.99 | 99.99 |
| 300 | 99.99 | 99.99 |
Publisher’s Note: MDPI stays neutral with regard to jurisdictional claims in published maps and institutional affiliations. |
© 2022 by the authors. Licensee MDPI, Basel, Switzerland. This article is an open access article distributed under the terms and conditions of the Creative Commons Attribution (CC BY) license (https://creativecommons.org/licenses/by/4.0/).
Share and Cite
Xia, Y.; He, L.; Feng, J.; Xu, S.; Yao, L.; Pan, G. Waterproof and Moisture-Permeable Polyurethane Nanofiber Membrane with High Strength, Launderability, and Durable Antimicrobial Properties. Nanomaterials 2022, 12, 1813. https://doi.org/10.3390/nano12111813
Xia Y, He L, Feng J, Xu S, Yao L, Pan G. Waterproof and Moisture-Permeable Polyurethane Nanofiber Membrane with High Strength, Launderability, and Durable Antimicrobial Properties. Nanomaterials. 2022; 12(11):1813. https://doi.org/10.3390/nano12111813
Chicago/Turabian StyleXia, Yong, Lifen He, Jundan Feng, Sijun Xu, Lirong Yao, and Gangwei Pan. 2022. "Waterproof and Moisture-Permeable Polyurethane Nanofiber Membrane with High Strength, Launderability, and Durable Antimicrobial Properties" Nanomaterials 12, no. 11: 1813. https://doi.org/10.3390/nano12111813
APA StyleXia, Y., He, L., Feng, J., Xu, S., Yao, L., & Pan, G. (2022). Waterproof and Moisture-Permeable Polyurethane Nanofiber Membrane with High Strength, Launderability, and Durable Antimicrobial Properties. Nanomaterials, 12(11), 1813. https://doi.org/10.3390/nano12111813
